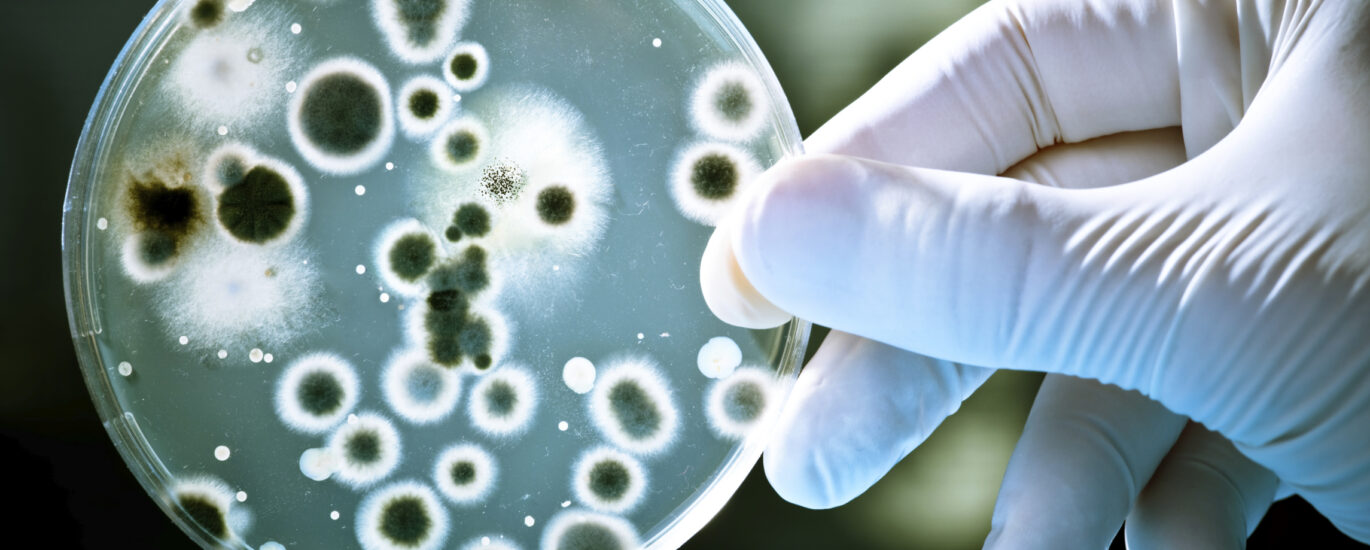

While bacterial infections and viral infections are extremely common, both come with their own particular set of mild and severe risks. To reduce your facility’s risk of exposure, it’s important to first understand the difference between a virus and bacteria. Use this guide from ServiceMaster Clean to learn what viral and bacterial infections are, what risks they pose, and how you can limit your exposure to them.
Bacterial infections are single-celled microorganisms that can survive on their own. Some bacteria are harmless, while other types can cause illness. Luckily, many of the more serious bacterial infections a person can get can be treated with antibiotics. Bacterial infections are typically derived from the following causes.
Viral infections are smaller than bacteria, and require a living host to remain active. Like bacterial infections, some types of viral infections are harmless, while other strands can do serious damage. Viral infections are typically derived from the following causes.

We know how dangerous bacteria and viruses can be if left unchecked. That’s why our healthcare janitorial services were built around infection control prevention, risk reduction, and environment improvement. Using the best practices and procedures set in place by OSHA and other leading industry organizations, our expert staff can deliver a deep clean in your facility.
While bacterial infections and viral infections are extremely common, both come with their own particular set of mild and severe risks. To reduce your facility’s risk exposure, it’s important to first understand the difference between a virus and bacteria. Use this guide from ServiceMaster Clean to learn what viral and bacterial infections are, what risks they pose, and how you can limit your exposure to them.